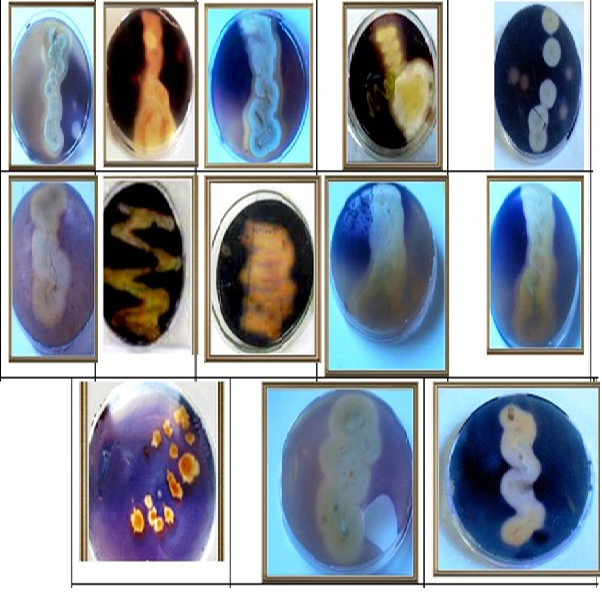
Screening for Antimicrobial Activities and Enzymatic Activities Production of Some Actinomycetes spp. Isolated from Different Soil Samples from Hilla Province

Vol. 3 No. 1 (2024)
Articles
-
Fungal Survey of Different Clinical Samples Collected from Patients
 DOI :
https://doi.org/10.5281/zenodo.15771842
DOI :
https://doi.org/10.5281/zenodo.15771842
 Abstract Views:
186
|
Abstract Views:
186
|
 Downloads:
73
Downloads:
73
-
Synthesis, Characterization and Theoretical Study of 2,4-diaryl-1,3-Selenazole
 DOI :
https://doi.org/10.5281/zenodo.15772101
DOI :
https://doi.org/10.5281/zenodo.15772101
 Abstract Views:
360
|
Abstract Views:
360
|
 Downloads:
212
Downloads:
212
-
Magnitude of Perinatal Mortality and Associated Factors among Babies born in Hospital Vadodara, Gujarat
 DOI :
https://doi.org/10.5281/zenodo.15773060
DOI :
https://doi.org/10.5281/zenodo.15773060
 Abstract Views:
168
|
Abstract Views:
168
|
 Downloads:
68
Downloads:
68